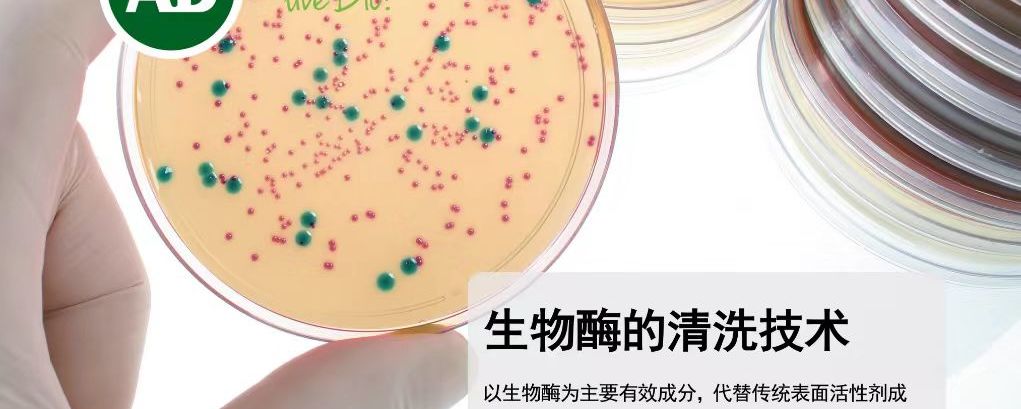

更多新闻

马利希旗下Abtex亮相SurfacePME2026,将展出精密毛刷与自动化技术深度融合的一体化去毛刺解决方案
展会新闻
东莞马利希清洁器材有限公司
自1980年以来,Abtex专注为制造商提供一体化去毛刺解决方案,通过精密毛刷与自动化技术深度融合,始终致力于提升工件品质,加工一致性与生产效率。

上海脉诺&中创微亮相SurfacePME2026,将展出成熟的电化学抛光、 阳极氧化、化学洗净,内衬四氟等加工工艺
展会新闻
上海脉诺金属表面处理技术有限公司
中创微(浙江)半导体科技有限公司
金属表面处理完整解决方案提供商:一家专业从事不锈钢、铝合金、钛合金等金属材料表 面处理设备制造、金属表面处理药剂生产、表面处理加工工艺及新技术研发服务的高科技型企业。

湛临仪器亮相SurfacePME2026,将展出工业清洗工艺控制和零件油污清洁度检测技术
展会新闻
湛临(上海)仪器设备有限公司
工业清洗工艺控制和零件油污清洁度检测

宁波航锐光整亮相SurfacePME2026,将展出异型复杂零部件抛光 去毛刺 清洗后处理整体解决方案
展会新闻
宁波航锐光整技术有限公司
异型复杂零部件后处理(抛光、去毛刺、清洁)全方案服务商

VOLLMER孚尔默亮相SurfacePME2026,将展出高效节能的超声波去毛刺系统
展会新闻
孚尔默(太仓)机械有限公司
ultraTEC 采用超声波去毛刺技术,在不造成任何原始材料去除的前提下,依然能够实现卓越的去毛刺效果,同时能耗更低。

厦门维科特(VCTO)亮相SurfacePME2026,将展出切割、打磨、抛光及定制化的磨料磨具系统解决方案
展会新闻
厦门维科特研磨材料有限公司
厦门维科特(VCTO)作为专业磨料磨具厂商,为你提供切割,打磨,抛光及定制化系统解决方案。

伶机智能亮相SurfacePME2026,将展出首创的柔性自适应超精密光整加工机床,完全替代手工,实现了"尖边去毛刺”的高效量产!
展会新闻
上海伶机智能科技有限公司
首创柔性自适应超精密光整加工机床。专业研发生产去毛刺、研磨、抛光设备。完全替代手工,实现了"尖边去毛刺”的高效量产。

星星研磨亮相SurfacePME2026,将展出去毛刺、倒角、热处理后制程、镀层前制程等一站式自动化解决方案。
展会新闻
湖州星星研磨有限公司
专注产品表面去毛刺、倒角、热处理后制程、镀层前制程等一站式自动化解决方案。

拓毕新材料亮相SurfacePME2026,将展出光纤连接器、精密光学器件、精密陶瓷器件、高硬度热喷涂层的研磨及抛光材料
展会新闻
上海拓毕新材料科技有限公司
专注光纤连接器、精密光学器件、精密陶瓷器件、高硬度热喷涂层的研磨及抛光